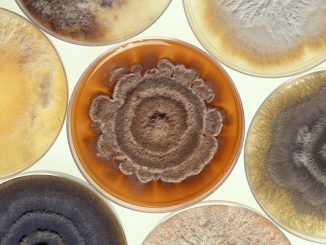
moisissure noire dans la maison que dangereuse

Un bon remède contre les puces pour les chats est celui qui donne un effet rapide et durable.
Salutations! Ils ont donné à ma nièce un beau chat pour son anniversaire. L'enfant était très content de ce cadeau, car il rêvait depuis longtemps d'un animal de compagnie. Mais un peu […]